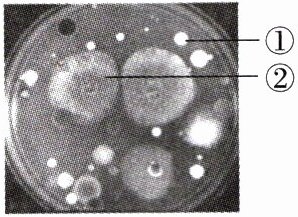

第64页
- 第1页
- 第2页
- 第3页
- 第4页
- 第5页
- 第6页
- 第7页
- 第8页
- 第9页
- 第10页
- 第11页
- 第12页
- 第13页
- 第14页
- 第15页
- 第16页
- 第17页
- 第18页
- 第19页
- 第20页
- 第21页
- 第22页
- 第23页
- 第24页
- 第25页
- 第26页
- 第27页
- 第28页
- 第29页
- 第30页
- 第31页
- 第32页
- 第33页
- 第34页
- 第35页
- 第36页
- 第37页
- 第38页
- 第39页
- 第40页
- 第41页
- 第42页
- 第43页
- 第44页
- 第45页
- 第46页
- 第47页
- 第48页
- 第49页
- 第50页
- 第51页
- 第52页
- 第53页
- 第54页
- 第55页
- 第56页
- 第57页
- 第58页
- 第59页
- 第60页
- 第61页
- 第62页
- 第63页
- 第64页
- 第65页
- 第66页
- 第67页
- 第68页
- 第69页
- 第70页
- 第71页
- 第72页
- 第73页
- 第74页
1. 细菌和大部分真菌都很小,通过配制的培养基可以得到如图所示的细菌菌落和真菌菌落。下列有关说法中,错误的是(

A.图中的①表示细菌菌落,②表示真菌菌落
B.琼脂煮沸冷却后成为培养菌落用的固体培养基
C.细菌或真菌的接种需在灭菌后的培养基上进行
D.菌落是由一个或多个细菌或真菌繁殖后形成的肉眼可见的子细胞群体
B
)
A.图中的①表示细菌菌落,②表示真菌菌落
B.琼脂煮沸冷却后成为培养菌落用的固体培养基
C.细菌或真菌的接种需在灭菌后的培养基上进行
D.菌落是由一个或多个细菌或真菌繁殖后形成的肉眼可见的子细胞群体
答案:
1.B
2. 科研人员从某盐碱湖中分离出了一些极端耐盐菌(细菌),这表明(
A.细菌都能生存在极端环境中
B.细菌的生存不需要特定的条件
C.细菌在生物圈中分布广泛
D.耐盐菌的生存离不开高盐环境
C
)A.细菌都能生存在极端环境中
B.细菌的生存不需要特定的条件
C.细菌在生物圈中分布广泛
D.耐盐菌的生存离不开高盐环境
答案:
2.C 题述现象说明细菌的适应能力很强,由此说明细菌的分布广泛。
3. 若将下列装置放置在 28℃的恒温箱中一周,其内微生物繁殖最多的是(

A.未煮过的牛肉汁和盐水
B.未煮过的牛肉汁和醋
C.未煮过的牛肉汁
D.煮过的牛肉汁
C
)
A.未煮过的牛肉汁和盐水
B.未煮过的牛肉汁和醋
C.未煮过的牛肉汁
D.煮过的牛肉汁
答案:
3.C 细菌和真菌的生活需要一定的条件,如水、适宜的温度、有机物等。盐水会抑制细菌、真菌的生长和繁殖,因此,A装置内微生物数量较少;醋有杀菌作用,也能抑制细菌、真菌的生长和繁殖,因此,B装置内微生物数量较少;未煮过的牛肉汁里细菌、真菌较多,营养物质丰富,细菌、真菌生长和繁殖较快,因此,C装置内微生物数量最多;煮过的牛肉汁经过高温杀菌,里面的细菌、真菌数量较少,繁殖较慢,因此,D装置内微生物数量较少。
4. 破伤风是伤口感染了破伤风杆菌引起的,当伤口暴露在外时,破伤风杆菌不能繁殖,当伤口深、坏死组织多、隔绝空气时,破伤风杆菌才能生长、繁殖。说明破伤风杆菌的生长、繁殖不需要(
A.水
B.二氧化碳
C.氧气
D.阳光
C
)A.水
B.二氧化碳
C.氧气
D.阳光
答案:
4.C 破伤风杆菌在伤口深、隔绝空气时才能生长、繁殖,说明破伤风杆菌的生活不需要氧气。
5. (2025 合肥经开区期末) 某校生物学兴趣小组对“检测不同环境中的细菌和真菌”探究实验做了如下设计。
第一步:将 4 个装有牛肉汁培养基的培养皿(已高温灭菌)贴上标签纸后分为 A、B 两组,A 组编号为 1 号和 2 号,用于检测教室的空气,B 组编号为 3 号和 4 号,用于检测笔帽。
第二步:将 4 个培养皿做如下处理。

第三步:每天观察一次,并做好记录。
根据上述实验设计,回答下列问题。
(1) 你认为这两组实验的对照组应该是__________培养皿。
(2) 有同学认为,4 号培养皿做“打开盖”这一步是多此一举,你认为是否需要做这一步?
(3) 下图是 3 天后观察到的 A、B 两组实验现象,根据实验现象,你得出的实验结论是

第一步:将 4 个装有牛肉汁培养基的培养皿(已高温灭菌)贴上标签纸后分为 A、B 两组,A 组编号为 1 号和 2 号,用于检测教室的空气,B 组编号为 3 号和 4 号,用于检测笔帽。
第二步:将 4 个培养皿做如下处理。

第三步:每天观察一次,并做好记录。
根据上述实验设计,回答下列问题。
(1) 你认为这两组实验的对照组应该是__________培养皿。
(2) 有同学认为,4 号培养皿做“打开盖”这一步是多此一举,你认为是否需要做这一步?
需要
,理由是保证变量唯一
。(3) 下图是 3 天后观察到的 A、B 两组实验现象,根据实验现象,你得出的实验结论是
教室的空气和笔帽上都有细菌和真菌
。观察 1 号培养皿发现,菌落 1 呈黑色、绒毛状,应该是真
菌菌落。
答案:
5.解析:
(1)1号和2号用于检测教室的空气,变量是教室空气;3号和4号用于检测笔帽,变量是笔帽。其中2号和4号起对照作用。
(2)在科学实验中,往往只选择一个变量。为研究变量对研究对象的影响,需要设计对照实验,这样可以增强实验结论的说服力。在对照实验中,除了已选择的实验变量不同外,其他条件应完全相同。在该实验中,设计4号培养皿做“打开盖”这一步是保证变量唯一。
(3)图中1号和3号有大量细菌和真菌,2号几乎没有,4号有少量细菌和真菌。说明教室的空气和笔帽上都有细菌和真菌。真菌菌落较大,真菌中的霉菌形成的菌落常呈绒毛状、絮状或蜘蛛网状。菌落1呈黑色、绒毛状,应该是真菌菌落。
答案:
(1)2号和4号
(2)需要 保证变量唯一
(3)教室的空气和笔帽上都有细菌和真菌 真
(1)1号和2号用于检测教室的空气,变量是教室空气;3号和4号用于检测笔帽,变量是笔帽。其中2号和4号起对照作用。
(2)在科学实验中,往往只选择一个变量。为研究变量对研究对象的影响,需要设计对照实验,这样可以增强实验结论的说服力。在对照实验中,除了已选择的实验变量不同外,其他条件应完全相同。在该实验中,设计4号培养皿做“打开盖”这一步是保证变量唯一。
(3)图中1号和3号有大量细菌和真菌,2号几乎没有,4号有少量细菌和真菌。说明教室的空气和笔帽上都有细菌和真菌。真菌菌落较大,真菌中的霉菌形成的菌落常呈绒毛状、絮状或蜘蛛网状。菌落1呈黑色、绒毛状,应该是真菌菌落。
答案:
(1)2号和4号
(2)需要 保证变量唯一
(3)教室的空气和笔帽上都有细菌和真菌 真
查看更多完整答案,请扫码查看


